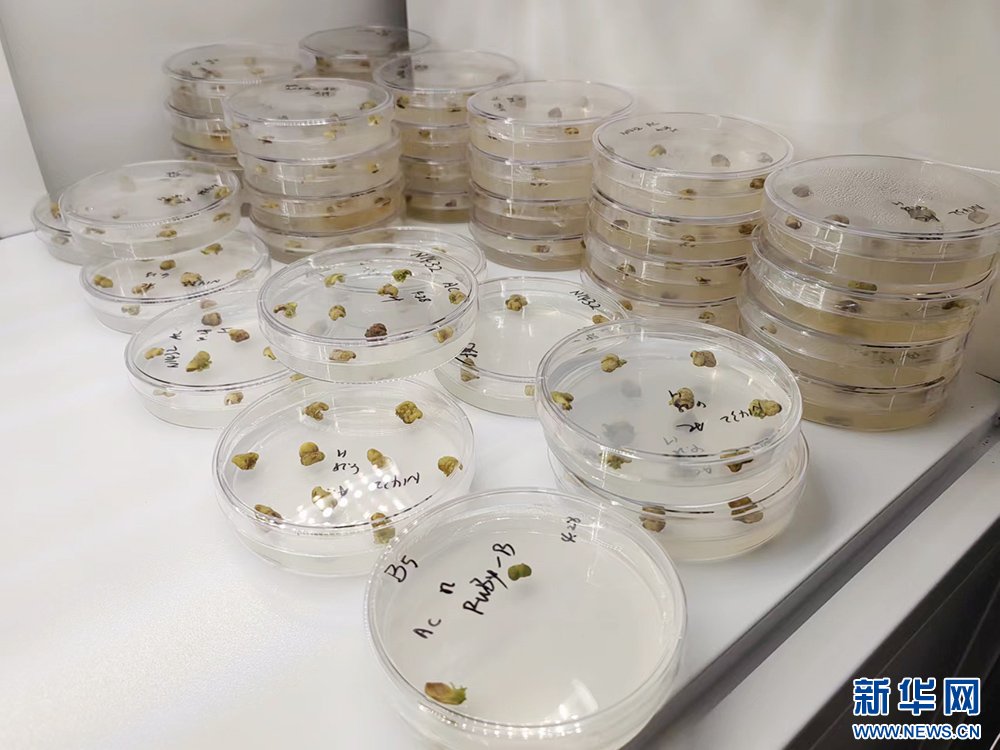

新华网武汉7月3日电(刘晓丽、王璐、杨凯)种子是农业的“芯片”,种业发展离不开科技创新。湖北是农业大省,种质资源丰富,武汉高校众多,科研资源聚集。近年来,武汉市加快推进武汉国家现代农业产业科技创新中心(武汉国家农创中心)和种都建设一体发展,致力于打造种业高质量发展策源地。
农创中心频现种业“黑科技”
水里游的全雄马口鱼,地里种的太空南瓜、彩色西瓜,展馆里展示的基因编辑植物种子和幼苗,田间跑的无人驾驶智慧农机……近日,2024武汉种业博览会在观展嘉宾和市民啧啧称奇中落下帷幕。这些“黑科技”集中亮相,是武汉强化科技兴农的成果。
在位于武汉国家农创中心高农生物园的武汉艾迪晶生物科技有限公司,从种子消毒、接种到培养基,到分离愈伤组织、浸染、接种到分化培养基,再到对抗性植株进行生根、练苗……经过一系列繁琐的生物育种基因编辑过程,一粒种子能产生脱胎换骨的变化。
接种到分化培养基里的植物种子。新华网刘晓丽摄
艾迪晶生物遗传部主管邓慧杰说:“基因编辑就像一把剪刀,能够对植物基因组特定位置的基因进行修饰、插入或突变,从而获得想要的植物性状。”
4月,武汉首个由政府认定的生物育种公共服务平台“功能基因研究和应用公共服务平台”在武汉国家农创中心授牌,服务平台由2023年入驻武汉农创中心中国种都大厦的武汉伯远生物科技有限公司建设运营。
武汉伯远生物科技有限公司副总经理金杰说:“与传统杂交育种相比,通过一站式研发平台,能够快速迭代出产品,进入市场化运作。通过通量规模的载体构建平台、遗传转化平台、检测平台、蛋白实验平台、合成生物学平台等,伯远生物可支撑上万个种业公司的研发需求。”

伯远生物实验室。新华网刘晓丽摄
马口鱼是重要的小型经济鱼类。自然水域中,雄马口鱼不仅体型显著大于雌鱼,生长速度也要快1.5倍以上。近年来,育种专家们致力探索培育全雄性马口鱼。
经过努力,湖北黄优源渔业公司联合华中农业大学水产学院合力攻坚,获得马口鱼超雄父本,经3代及以上群体选育获母本,子代即全雄选育马口鱼,雄性率约80%,在国内处于领先地位。

“黄优源”版全雄马口鱼。新华网刘晓丽摄
“黄优源”版全雄选育马口鱼生长周期由一年缩短至半年左右,可有效提高马口鱼养殖效益。
本地种业走出国门
6月3日,在2024武汉种业博览会上,湖北种业企业与共建“一带一路”国家签约合作引起广泛关注。当天,武汉庆发禾盛农业发展有限公司与土耳其企业签约,参与土耳其蔬菜商业化定向育种。
在武汉庆发禾盛农业发展有限公司,“湖北一粒油菜籽 巴铁一壶健康油”标语醒目。庆发禾盛国际贸易部经理周旭升说:“公司最早在海外推广的是油菜种子,我们从2009年开始,联合育种专家试验选育杂交油菜品种,最终从200多个油菜品种中选育出新品种‘HC-021C’,并于2019年成功商业化。”
据介绍,“HC—021C”是首个在巴基斯坦成功注册的外国油菜品种,这种单位产量较其他可增产约5%的品种受到巴基斯坦农户欢迎。去年,庆发禾盛在当地推广种植此油菜品种60万亩。

庆发禾盛油菜种子HC—021C及其产品。新华网发
除此之外,庆发禾盛还在海外注册水稻品种8个,海外定向育种西甜瓜、西葫芦、抗热蔬菜等,已在孟加拉、巴基斯坦等国实现量产销售,涉及欧洲、南美及非洲市场。
湖北惠民农业科技有限公司是湖北首家取得海关AEO高级认证企业证书的农业企业,今年上半年,公司出口中亚的棉花种子达1300吨,占全国43%。
近日,湖北惠民农业科技有限公司与乌兹别克斯坦企业签约,将在乌兹别克斯坦成立棉种加工厂,这将是中亚地区首个育、繁、推一体化棉花种子公司。
武汉市农业农村局科技与种业管理处相关负责人介绍,湖北种业企业参与共建“一带一路”起步较早。1999年,湖北省种子集团就开始开拓国际市场,业务范围涉及亚、欧、非及南美洲20多个国家和地区,年出口水稻、棉花、油菜、玉米等种子2000吨左右。武汉国英种业公司与武汉大学共建研发中心联合选育的“珞优8号”是中国杂交稻种子出口量最大的品种,“珞优8号”和“珞优9348”在海外累计推广超1000万亩,“红莲稻”种子出口占我国每年出口杂交稻种子总量超80%。
资源聚合激发农业“链式效应”
武汉市农业农村局副局长王文高说:“我们计划将武汉国家农创中心打造成农业高质量发展策源地,围绕推动农业科技升级、打造优势产业集群、加速推动成果转化、持续培塑农创品牌和提升科创服务功能五大目标,在靶向招商、引进高端人才、承接重大项目、成果产业化、举办会展活动、开展社会化服务等方面集中发力,目前发展快速。”
作为全国第五个、华中地区唯一一个国家现代农业产业科技创新中心,经过集聚培育,武汉国家农创中心已有700余家农业科技企业落户,先后诞生全球首张水稻基因组育种芯片、全球第一支试管藕、全国第一个双低油菜品种,优质柑橘、水生蔬菜、淡水鱼、优质瘦肉猪、高效动物疫苗等近百项国际国内领先成果。

武汉国家农创中心。新华网刘晓丽摄
为实现科技创新成果转化,武汉国家农创中心集聚培育优质企业,实施了“上市公司、独角兽企业、瞪羚企业、高新技术企业”分层培育计划。目前,武汉农创中心聚集世界500强企业5家、上市公司15家、高新技术企业154家、瞪羚企业48家,涉及生物种业、动物生物制品和生物饲料添加剂等三大主导产业。
“武汉国家农创中心就像一个大‘媒婆’,将科研人员、企业和成果集中,建成数据库,通过交易会、推介会等系列活动在产业链条上精准推出。未来,湖北各市州的农业产业也将通过武汉国家农创中心串联起来,产业链范围将进一步延展。”王文高说。
目前,武汉国家农创中心引导湖北省种子协会、武汉市种业协会联合打造武汉市种业全产业链,全省80%以上种企落户武汉,年推广种植面积超过7000万亩,武汉种业全产业链产值达850亿元。
Copyright © 2001-2026 湖北荆楚网络科技股份有限公司 All Rights Reserved
互联网新闻信息许可证 4212025003 -
增值电信业务经营许可证 鄂B2-20231273 -
广播电视节目制作经营许可证(鄂)字第00011号
信息网络传播视听节目许可证 1706144 -
互联网出版许可证 (鄂)字3号 -
营业执照
鄂ICP备 13000573号-1
鄂公网安备 42010602000206号
版权为 荆楚网 www.cnhubei.com 所有 未经同意不得复制或镜像